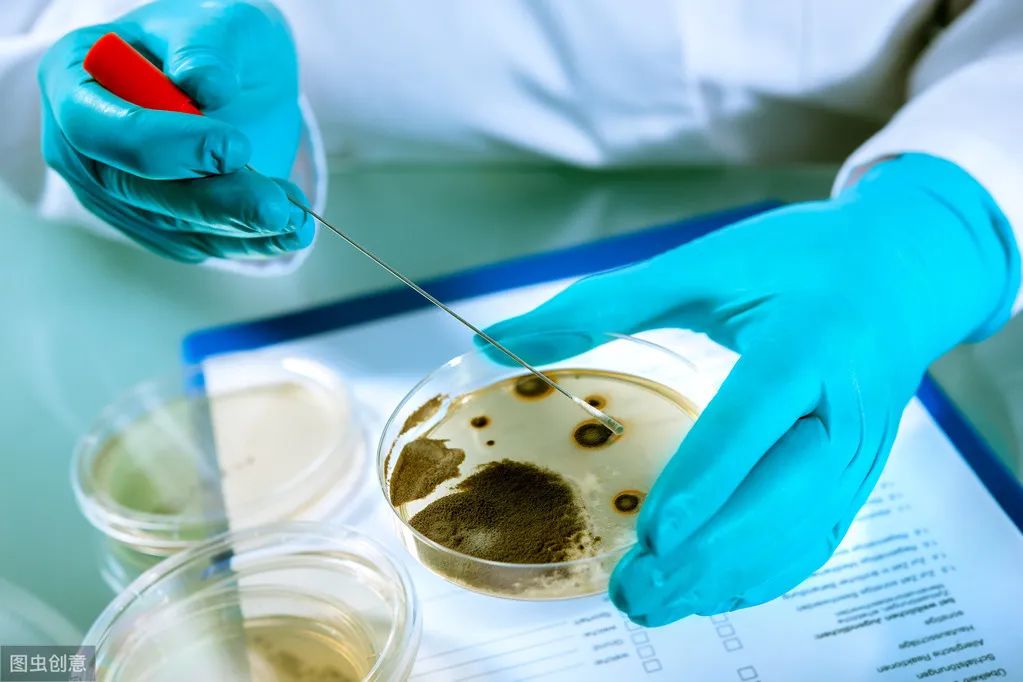
冰箱断电食物发臭如何除臭味,冰箱发臭一进门就闻得到怎么办

冰箱有"发臭杀手",随时夺人性命!开水烫不死,放个"蛋"才能解决
1910年世界上第一台压缩式制冷冰箱在美国问世,我们中国从50年*开代**始生产电冰箱。

现在家家户户基本都用上了冰箱,平常吃的喝的,我们都放在冰箱里,可以保鲜不易坏。
可是冰箱不是保险箱,还有可能是细菌定时*弹炸**!

你绝对想不到,冰箱是家中仅次于卫生间第二脏的地方;剩饭、剩菜、生肉、果蔬混在一起抽屉带菌量超过安全标准750倍。

我们要注意冰箱内的卫生,稍微不小心就可能吃出“冰箱病”;例如李斯特菌引起的腹泻、腹痛、昏迷等。
李斯特菌广泛存在于自然界中,包括土壤、水域、昆虫、植物、蔬菜、鱼、鸟、野生动物、家禽等都曾发现它的身影,国际上公认的李斯特菌共有十个菌株,但是真正能引起人类疾病的只有单增李斯特菌一种。
李斯特菌可以通过接触眼睛和破损皮肤进入人体内,不过多数情况下就是吃进去的,它的主要传染媒介是食物,是最致命的食源性病原体之一。

最特别的是,李斯特菌还是一种厌氧菌,在无氧条件下,李斯特菌侵袭力会比正常情况下高出100多倍。
所以李斯特菌被称为“冰箱杀手”,主要原因是李斯特菌能在2~42℃下生存,是冷藏食品威胁人类健康的主要病原菌之一。食品中存在的单核李斯特菌会引发人类的生命安全!

近期,杭州一名50岁男子因为吃了冰箱放了一周的猪蹄,竟然昏迷休克,还好抢救回来了。

那怎样知道冰箱脏不脏呢?最直接的办法就是,如果你一打开冰箱就闻到异味,这说明冰箱细菌已经严重超标了;你就得注意冰箱的卫生问题,因为异味就是细菌代谢产生的。

那要选择什么来杜绝这种情况?
今天小编就得给大家推荐日本黑科技 小黄鸡硅藻除味蛋,杀菌祛味双效合一!

这款除味蛋能够祛除异味
还能有效杀菌
在冰箱里放一颗
不但刺鼻的臭味被吸得干干净净
而且危害健康的细菌也通通被杀死
同时也能当干燥剂
干燥空气

1、优选上等硅藻土,匠心制造
这款除味蛋由北海道天然硅藻土制成
来自日本北海道的硅藻遗骸
经过数十亿年的不断沉积
形成了表面具有无数密孔的硅藻土
纯天然,不含异味和有害物质
人们称它为“会呼吸的活化石”

科学研究证明
硅藻土对甲醛等有害气体的吸附能力
是活性炭的5000-6000倍!
空气中的有害气体
没一会就被它吸得一干二净

日本人早在几十年前
还有一大堆的硅藻土衍生品
硅藻澡盆、杯垫、浴室澡垫
食品干燥剂,专业吸附一百年
只要想吸水,吸有害气体
认准硅藻土没错了!

这款除味蛋精选天然硅藻土
另外添加活性竹炭
超强的吸附除菌能力
甩传统竹炭包好几条街
堪称除臭界的冠军

2、99%抑制细菌,李斯特菌克星
硅藻土的主要成分硅酸质
具有杀菌功能
既能祛除异味
同时又能有效杀灭大肠杆菌
李斯特菌等有害细菌

冰箱里放一颗硅藻土除味蛋
异味没有了
细菌不再滋生
就算长期不清洗也依然保持干净整洁

平时我们喜欢把新鲜食物放入冰箱
但并不能保鲜多长时间
食物没过几天就坏了
如果放进一颗除味蛋
保鲜期至少延长3倍

没放除味蛋的冰箱里的猪肉
两天就发臭了
而放了除味蛋的猪肉
放了一周还依然新鲜

水果也一样
没放除味蛋的苹果不到10天就坏了
而放了的仍然鲜嫩饱满

3、会呼吸的活化石,让异味无所遁形
日本岩崎硅藻土除臭蛋
由高达60%的硅藻土+活性炭制成
除异味能力相当于500包活性炭
适用于多个生活场所

异味在很大程度上都是由于细菌产生的
这颗除臭蛋拥有着强大的杀菌作用
细菌没了,异味的根源消失
外加其对异味有着强大的吸附力
除异味效果可以说快速且持久

冰箱中放一放
葱蒜味、鱼腥味,还有各种串味
第二天就全部消失
有了它食物随便放
再也不怕串味了

用在卫生间里除臭
连空气清新剂都不用买了
空气清新剂一段时间就用完了
它却可以使用一年之久
性价比可以说很高了

4、无惧南风天,干燥清爽一整天
岩崎硅藻蛋的吸湿能力强大
在实验中硅藻蛋一放入水中
水位线就急速下降
吸水效果惊人
冰箱中容易积水
用岩崎硅藻蛋再合适不过
水洗干净了,不仅能防止食物冻坏
还能增加冰箱的使用寿命

这款日本原料制作的小黄鸡冰箱除臭蛋,价格也不贵,原价39块钱每盒,现在活动价仅2盒才39.9块。一份快餐、一包烟的钱,就可以搞定一年的异味和家人健康保障。
快点击下面进入购买↓
【特惠2盒39.9】冰箱除味剂100g
¥39.9
购买